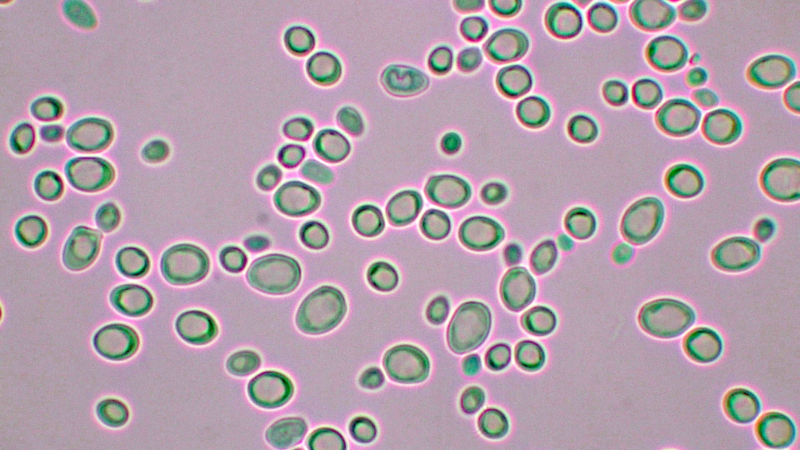
ハルニレの木からワインが生まれた。新冠町でオリジナルワイン「ピポク」誕生

ハルニレの木からワインが生まれた。新冠町でオリジナルワイン「ピポク」誕生
掲載日:2026.04.01
新冠の「風土」を、科学の力で一滴に。
野生酵母の分離からラベルデザインまで。
地域のアイデンティティを醸成する。
〜株式会社シティック×発酵科学研究室:新冠町テロワールワイン開発プロジェクト〜
【この活動のポイント】
- 自然界からの贈り物: 新冠町のハルニレから分離した野生酵母を使用。その土地にしかない「テロワール」を反映したワイン造り。
- 高度な分析技術: DNA塩基配列解析により酵母(M. pulcherrima)を同定。市販酵母との最適な組み合わせで、安定した品質を確保。
- 文化を纏うデザイン: アイヌ語で「岩の陰」を意味する「ピポク」と命名。地域の景勝地や馬産地の歴史を込めたラベルを考案。
【活動紹介】
「その土地にしかない味」を、ミクロの世界から探し出す
ワイン産業において、土地の個性を表す「テロワール」は最も重要な価値の一つです。発酵科学研究室では、株式会社シティックと共同で、新冠町の植物試料からオリジナルワインにふさわしい「野生酵母」を分離する取り組みを行いました。
ハルニレから見つかった、優れたポテンシャル
新冠町の様々な草花を調査した結果、ハルニレの木から分離した酵母株が、赤ワイン用ブドウ「山幸」のジュースにおいて極めて良好な発酵特性を示すことを発見しました。 DNA解析によりこの酵母を同定し、長期にわたる発酵試験を実施。品質の安定性を科学的に証明することで、野生酵母ならではの深みと、プロの製品としての信頼性を両立させました。
地名に刻まれた記憶を、ラベルに込めて
完成したワインは、アイヌ語で「岩の陰」を意味する「ピポク」と名付けられました。 ラベルデザインには、名前の由来となった新冠町の景勝地「判官舘(はんがんだて)」のモチーフに加え、日本有数の馬産地であることに敬意を表し、馬の影が添えられています。 科学と文化が溶け合い、新冠町の誇りが詰まったこのワインは、地域の新しい魅力を世界へ発信します。